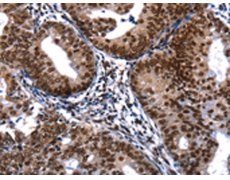
一抗

|
Background: |
Apoptosis is a cell death process that removes toxic and/or useless cells during mammalian development. The apoptotic process is accompanied by shrinkage and fragmentation of the cells and nuclei and degradation of the chromosomal DNA into nucleosomal units. DNA fragmentation factor (DFF) is a heterodimeric protein of 40-kD (DFFB) and 45-kD (DFFA) subunits. DFFA is the substrate for caspase-3 and triggers DNA fragmentation during apoptosis. DFF becomes activated when DFFA is cleaved by caspase-3. The cleaved fragments of DFFA dissociate from DFFB, the active component of DFF. DFFB has been found to trigger both DNA fragmentation and chromatin condensation during apoptosis. Two alternatively spliced transcript variants encoding distinct isoforms have been found for this gene. |
|
Applications: |
ELISA, IHC |
|
Name of antibody: |
DFFA |
|
Immunogen: |
Fusion protein of human DFFA |
|
Full name: |
DNA fragmentation factor, 45kDa, alpha polypeptide |
|
Synonyms: |
DFF1, ICAD, DFF-45 |
|
SwissProt: |
O00273 |
|
ELISA Recommended dilution: |
1000-5000 |
|
IHC positive control: |
Human cervical cancer and Human thyroid cancer |
|
IHC Recommend dilution: |
25-100 |

 購物車
購物車 幫助
幫助
 021-54845833/15800441009
021-54845833/15800441009